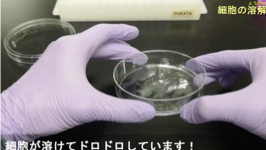

名古屋大学大学院医学系研究科 神経情報薬理学講座 深田研究室
シナプス伝達の生理と病態を説明する基本原理の解明を目指して












私共の研究室では、脳高次機能の基本機能単位であるシナプス伝達を調節する分子機構、さらには脳病態におけるその破綻機構の解明を目指しています。
具体的には、記憶や学習の分子基盤をなすAMPA型グルタミン酸受容体の制御機構について研究を展開しています。
現在は、主に
1)てんかん関連リガンド・受容体“LGI1・ADAM22”
2)タンパク質の細胞内局在を決定するパルミトイル化脂質修飾
に着眼して生化学、分子・細胞生物学、組織学、電気生理学、マウス遺伝学を駆使して研究を行っています。
共に興味を分かち合い、世界に情報発信したいと望む
若者を募集しています。
トピックス & インフォメーション(神経情報薬理学講座)
2026.4.22
木谷天音さんが「第35回基礎医学セミナー研究発表会」で最優秀賞を受賞しました。おめでとう!!
2026.4.7
浦田紗優さんが新たに加わりました
2026.3.24
Good luck Teh-san!!
2026.3.5
基礎医学セミナーが終了しました。
みなさん大変よく頑張りました。お疲れ様でした。
2025.9.29
平野瑶子さんが学位(医学_東大)を取得しました。おめでとう!!
2025.8.8
ドイツ・フライブルク大学生
Louis君の4ヶ月間のインターンシップが終了しました。
Good job!!
2024.10.1
Sijin Chen さんと、基礎医学セミナーの学生さん4名が新たに加わりました。
2024.9.13
総研大生、Teh Zhi Huiさんが学位(理学)を取得しました。おめでとう!!
2024.9.1
横井紀彦が名古屋大学大学院医学系研究科 神経情報薬理学講座の講師に昇進しました。
2024.6.6
「シナプス-ナノドメインの発見」に関する10周年 記念総説をJ Neurosci誌に発表しました。
フランスのHosy博士、オランダのMacGillavry博士、インドのNair博士との共同執筆です。
2024.4.1
GAO Jiaqiさんと清水亮至君が新たに加わりました。
2024.3.27
稲橋君、古川さん、原さん、長い間、研究室を支えて下さりありがとうございました。
総研大生、江川孝彦君が学位(理学)を取得しました。おめでとう!!
また、2024.3.31をもって深田研は、生理研 生体膜研究部門から
名古屋大学大学院医学系研究科 神経情報薬理学講座へ移行いたしました。
2024.3.8
基礎医学セミナーが終了しました。
みなさんよく頑張りました。ご苦労様でした。
2023.12.15
生命創成探求センター・生理研 村田和義先生との共著で、「in situ cryo-ET」に関する総説をJ Biochem誌に発表しました。
2023.10.29
「ADAM22てんかん脳症」に関する論文をBrain Commun誌に発表しました。
チェコとスロバキアの臨床医との国際共同研究の成果です。
2023.9.1
横井紀彦が名古屋大学大学院医学系研究科 神経情報薬理学講座の助教に着任しました。
2023年度は生理研で兼任を行います。
2023.8.31
天野睦紀准教授が退職されました。
これまでのご功績に敬意を表しますとともに、深田研の立ちあげにご尽力くださり感謝申し上げます。
2023.8.1
深田優子が名古屋大学大学院医学系研究科 分子細胞薬理学講座の准教授に着任しました。
2023年度は生理研で兼任を行います。
2023.6.1
宮﨑裕理が名古屋大学大学院医学系研究科 神経情報薬理学講座の助教に着任しました。
2023.4.1
深田正紀は名古屋大学大学院医学系研究科 神経情報薬理学講座に着任しました。
近日中に研究室が生理研から名大に移転します。
生理研では1年間クロスアポイントを行います。
トピックス & インフォメーション(生理研・生体膜研究部門)
生理研・生体膜研究部門のHPはこちら
2023.3.31
鈴木さん、渡辺さん、長い間ありがとうございました。
2023.1.6
生理研研究会"ナノ・メゾスケールから捉えるシナプス制御機構の新展開"の参加登録を開始しました。皆様奮ってご参加ください。
2022.12.26
2023年01月12日(木)にIngo Greger 博士 (MRC, UK)による所長招聘セミナーを開催します。
2022.12.15
大学院中間発表会で江川孝彦君(総研大5年一貫制4年)が優秀発表賞を受賞しました。 おめでとう!!
2022.5.2
袴田大晶君が「第31回基礎医学セミナー研究発表会」で最優秀賞を受賞しました。おめでとう!!
2022.4.5
「ADAM22てんかん脳症」に関する論文をBrain誌に発表しました。
17ヶ国の遺伝学者、臨床医との国際共同研究の成果です。
2021. 12.15
「てんかん関連タンパク質ADAM22の量的制御機構」に関する論文(Yokoi et al., Cell Reports)を発表し、プレスリリースしました。
京大 深井研究室、生理研 平林研究室等との共同研究です。
2020.11.7
生理研一般公開において、アウトリーチ用の動画がYouTubeにupされました。